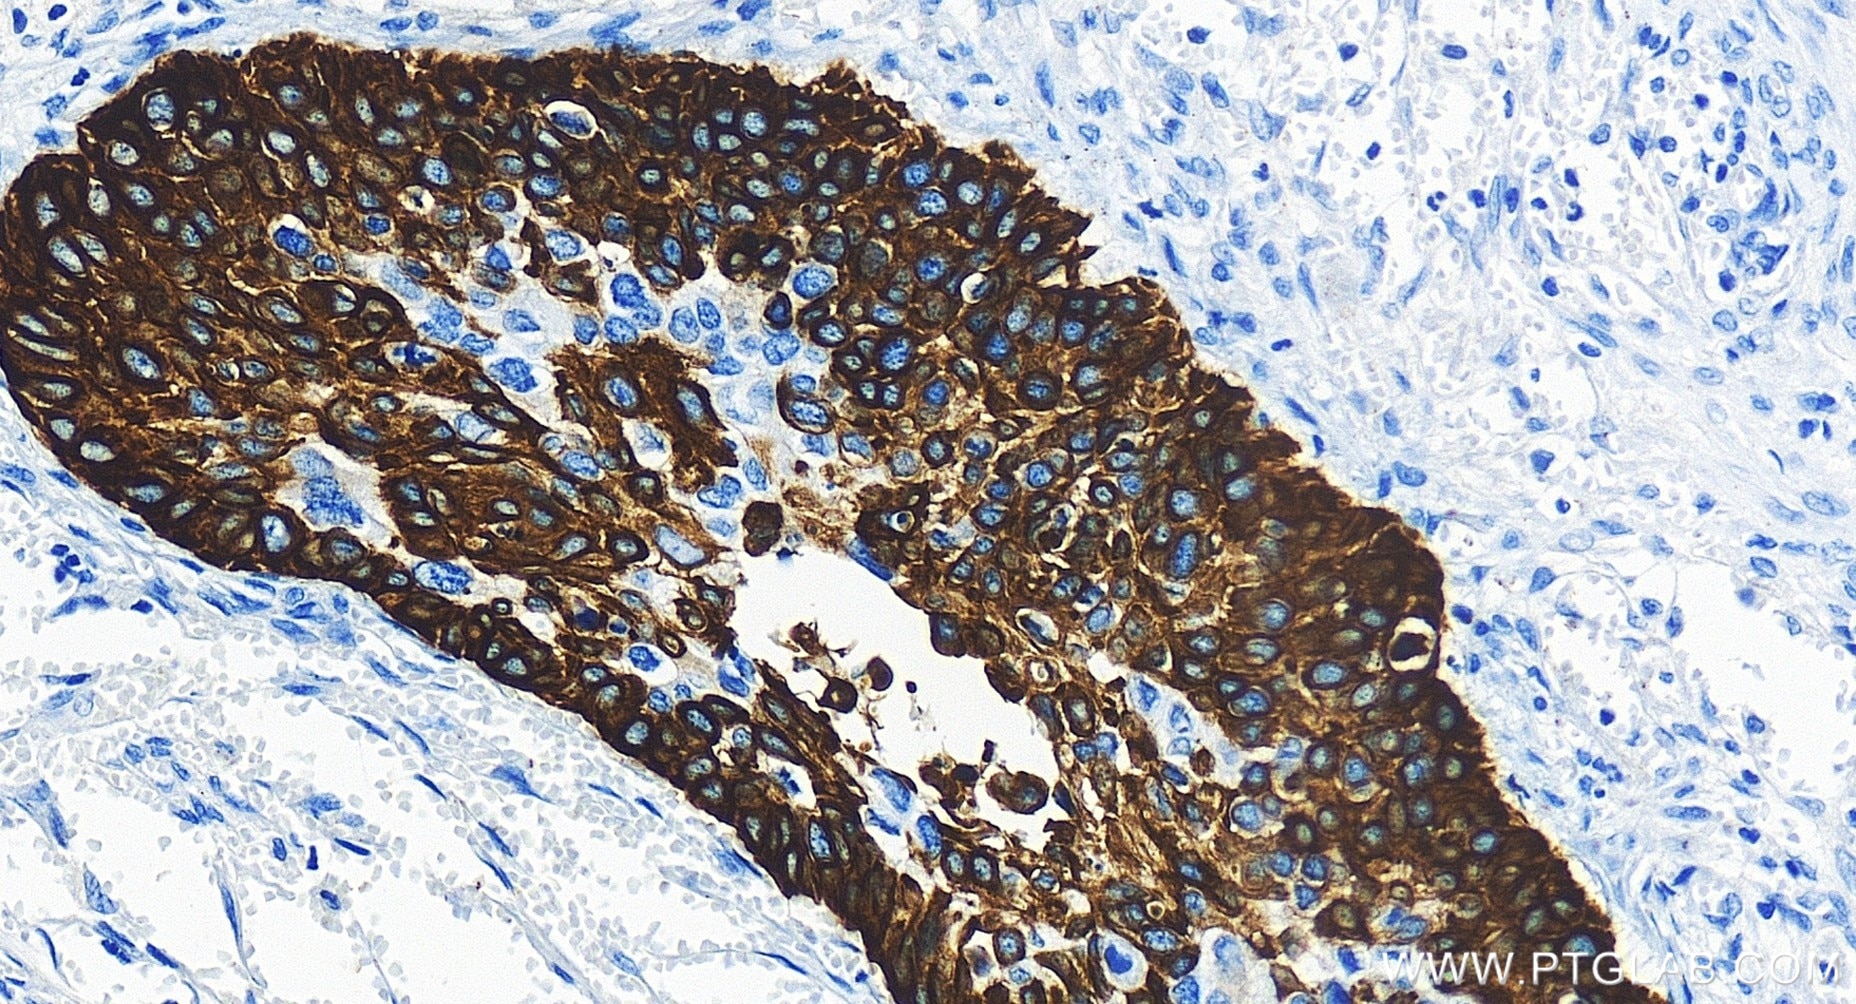
Immunohistochemical analysis of paraffin-embedded human cervical cancer tissue slide using 83379-1-RR (Cytokeratin 14 antibody) at dilution of 1:1000 (under 20x lens). Heat mediated antigen retrieval with Tris-EDTA buffer (pH 9.0). Immunohistochemistry (IHC) staining of human cervical cancer tissue using Cytokeratin 14 Recombinant monoclonal antibody (83379-1-RR)

Validation Data Gallery
Tested Applications
| Positive WB detected in | rat skin tissue |
| Positive IHC detected in | human cervical cancer tissue, human lung cancer tissue Note: suggested antigen retrieval with TE buffer pH 9.0; (*) Alternatively, antigen retrieval may be performed with citrate buffer pH 6.0 |
| Positive IF-P detected in | mouse skin tissue |
Recommended dilution
| Application | Dilution |
|---|---|
| Western Blot (WB) | WB : 1:500-1:2800 |
| Immunohistochemistry (IHC) | IHC : 1:500-1:2000 |
| Immunofluorescence (IF)-P | IF-P : 1:50-1:500 |
| It is recommended that this reagent should be titrated in each testing system to obtain optimal results. | |
| Sample-dependent, Check data in validation data gallery. | |
Product Information
83379-1-RR targets Cytokeratin 14 in WB, IHC, IF-P, ELISA applications and shows reactivity with human, mouse, rat samples.
| Tested Reactivity | human, mouse, rat |
| Host / Isotype | Rabbit / IgG |
| Class | Recombinant |
| Type | Antibody |
| Immunogen |
CatNo: Ag0188 Product name: Recombinant human KRT14 protein Source: e coli.-derived, PGEX-4T Tag: GST Domain: 262-472 aa of BC002690 Sequence: GQVGGDVNVEMDAAPGVDLSRILNEMRDQYEKMAEKNRKDAEEWFFTKTEELNREVATNSELVQSGKSEISELRRTMQNLEIELQSQLSMKASLENSLEETKGRYCMQLAQIQEMIGSVEEQLAQLRCEMEQQNQEYKILLDVKTRLEQEIATYRRLLEGEDAHLSSSQFSSGSQSSRDVTSSSRQIRTKVMDVHDGKVVSTHEQVLRTKN 相同性解析による交差性が予測される生物種 |
| Full Name | keratin 14 |
| Calculated molecular weight | 472 aa, 52 kDa |
| Observed molecular weight | 52 kDa |
| GenBank accession number | BC002690 |
| Gene Symbol | Cytokeratin 14 |
| Gene ID (NCBI) | 3861 |
| RRID | AB_3671033 |
| Conjugate | Unconjugated |
| Form | |
| Form | Liquid |
| Purification Method | Protein A purfication |
| UNIPROT ID | P02533 |
| Storage Buffer | PBS with 0.02% sodium azide and 50% glycerol{{ptg:BufferTemp}}7.3 |
| Storage Conditions | Store at -20°C. Stable for one year after shipment. Aliquoting is unnecessary for -20oC storage. |
Background Information
Cytokeratin 14, one of about 20 different cytokeratin isotypes of human cells, is the intermediate filament protein characteristic of epithelial cells. Cytokeratin 14 is expressed in the basal compartment of all stratified squamous epithelia. In various kinds of human tumors, the appearance and increasing expression of Cytokeratin 14 were strikingly associated with higher grade and stage of carcinoma, with varying degrees of unfavorable prognosis. In lung squamous cell carcinoma(LSCC), Cytokeratin 14 was expressed in the tumor cell nests showing stromal invasion with fibrosis and lymph node metastases, indicating that Cytokeratin 14 involved in proliferation and metastasis of LSCC. Cytokeratin 14 expression is sometimes used in diagnosis of myoepithelioma1 and intraductal vs. invasive ductal carcinoma of the breast.
Protocols
| Product Specific Protocols | |
|---|---|
| IF protocol for Cytokeratin 14 antibody 83379-1-RR | Download protocol |
| IHC protocol for Cytokeratin 14 antibody 83379-1-RR | Download protocol |
| WB protocol for Cytokeratin 14 antibody 83379-1-RR | Download protocol |
| Standard Protocols | |
|---|---|
| Click here to view our Standard Protocols |